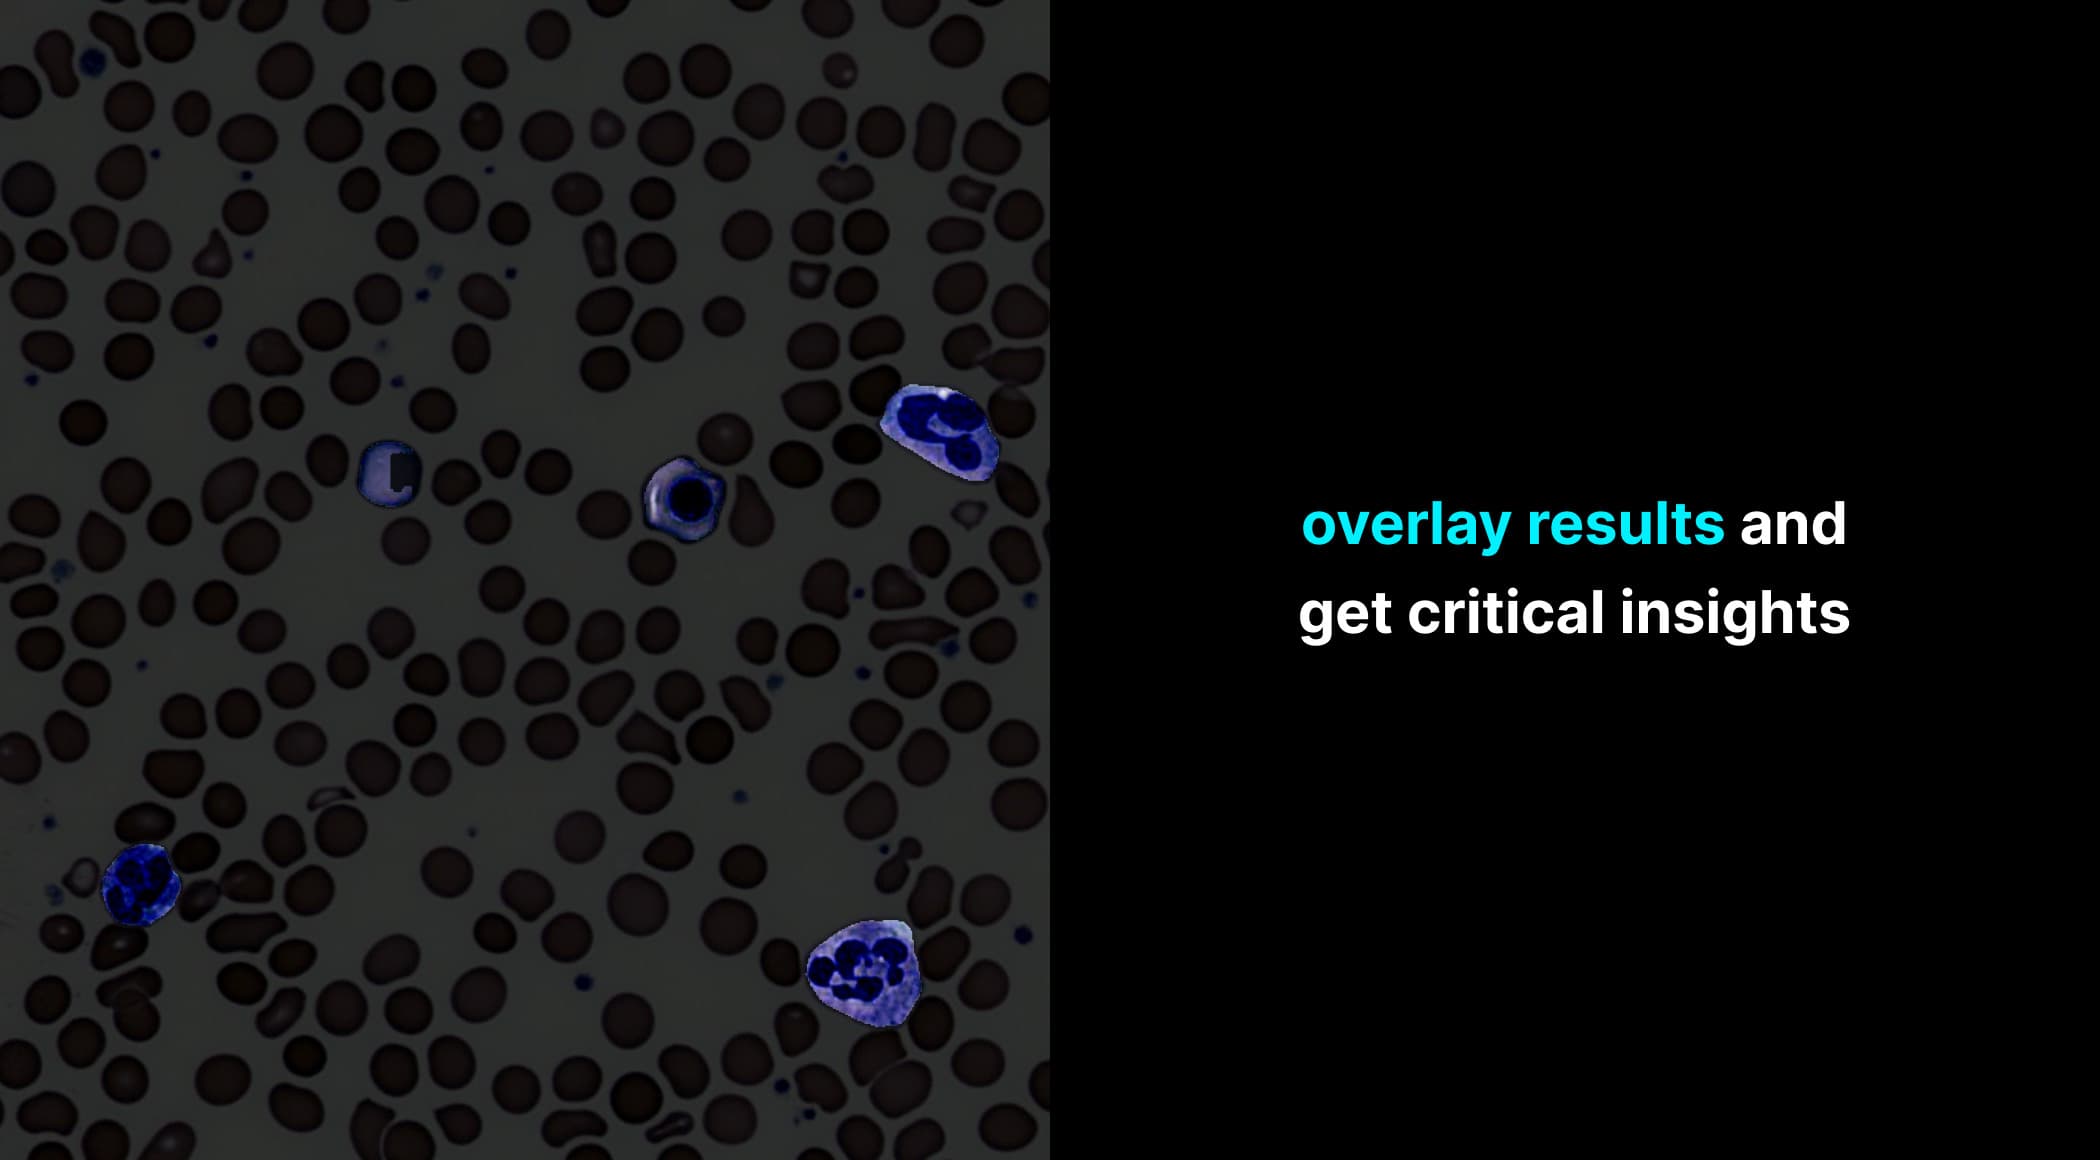
Gallery Image 5

BioSeg

Project Overview
Challenges
Category
Year
About
BioSeg offers a web-based tool for weakly-supervised cell segmentation in microscopic images using AI. It creates an efficient model requiring minimal data, addressing the challenge of scarce annotated cellular data. Vital in biomedical computing for tasks like cancer detection and drug discovery, this tool dramatically reduces manual annotation time from five hours to five seconds per image. BioSeg's innovative approach not only aids pathologists but also signifies a leap in computer vision segmentation.
Team
Gallery